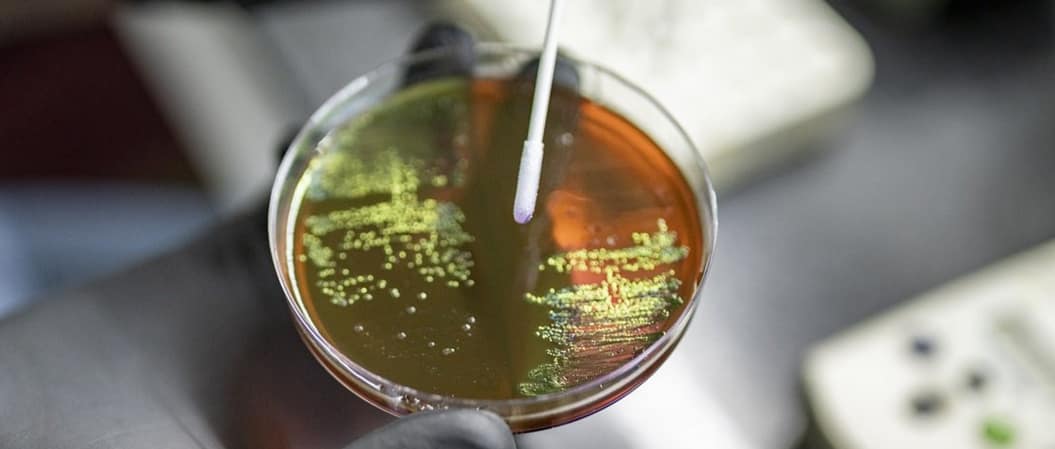
Bacteria

Researchers have discovered that bacteria can create “memories” about when to form bacterial swarms and develop antibiotic resistance.
Scientists have discovered that bacteria can create something like memories about when to form strategies that can cause dangerous infections in people, such as resistance to antibiotics and bacterial swarms when millions of bacteria come together on a single surface. The discovery — which has potential applications for preventing and combatting bacterial infections and addressing antibiotic-resistant bacteria — relates to a common chemical element bacterial cells can use to form and pass along these memories to their progeny over later generations.
Researchers at The University of Texas at Austin found that E. coli bacteria use iron levels as a way to store information about different behaviors that can then be activated in response to certain stimuli.
Scientists had previously observed that bacteria that had a prior experience of swarming (moving on a surface as a collective using flagella) improve subsequent swarming performance. The UT-led research team set out to learn why. Bacteria don’t have neurons, synapses or nervous systems, so any memories are not like the ones of blowing out candles at a childhood birthday party. They are more like information stored on a computer.

“Bacteria don’t have brains, but they can gather information from their environment, and if they have encountered that environment frequently, they can store that information and quickly access it later for their benefit,” said Souvik Bhattacharyya, the lead author and a provost early career fellow in the Department of Molecular Biosciences at UT.
It all comes back to iron, one of the most abundant elements on Earth. Singular and free-floating bacteria have varying levels of iron. Scientists observed that bacterial cells with lower levels of iron were better swarmers. In contrast, bacteria that formed biofilms, dense, sticky mats of bacteria on solid surfaces, had high levels of iron in their cells. Bacteria with antibiotic tolerance also had balanced levels of iron. These iron memories persist for at least four generations and disappear by the seventh generation.
“Before there was oxygen in the Earth’s atmosphere, early cellular life was utilizing iron for a lot of cellular processes. Iron is not only critical in the origin of life on Earth, but also in the evolution of life,” Bhattacharyya said. “It makes sense that cells would utilize it in this way.”
Researchers theorize that when iron levels are low, bacterial memories are triggered to form a fast-moving migratory swarm to seek out iron in the environment. When iron levels are high, memories indicate this environment is a good place to stick around and form a biofilm.
“Iron levels are definitely a target for therapeutics because iron is an important factor in virulence,” Bhattacharyya said. “Ultimately, the more we know about bacterial behavior, the easier it is combat them.”

Once-powerful antibiotics are losing their efficacy at a disconcerting pace as bacteria evolve immunity to our drugs. At least 700,000 people around the world now die each year from infections that could formerly be treated with antibiotics. A report last year from the United Nations Interagency Coordination Group on Antimicrobial Resistance warned that if no new major advances are made by 2050, mortality could leap to 10 million deaths a year.
What makes this prognosis all the more dire is that the antibiotic pipeline has slowed to a trickle. In the past two decades, only a few new antibiotics have been found that kill bacteria in novel ways, and rising resistance is a problem for all of them. Meanwhile, traditional methods of identifying antibiotics by screening natural compounds continue to come up short. Because of this, some researchers are now turning from the wet lab to silicon power in hopes of finding an answer.
The research was funded by the National Institutes of Health. Rasika Harshey, a professor of molecular biosciences and Mary M. Betzner Morrow Centennial Chair in Microbiology, is the senior corresponding author on the paper. Nabin Bhattarai, Dylan M. Pfannenstiel and Brady Wilkins, along with Abhyudai Singh of University of Delaware, also contributed to the research.

1 thought on “Bacteria Store “Memories” Raise New Red Flags for Antibiotic Resistance 2k23”